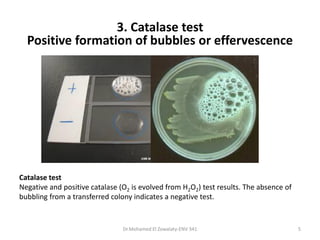
Dr.Mohamed El Zowalaty-ENV 341 5
Catalase test
Negative and positive catalase (O2 is evolved from H2O2) test results. The absence of
bubbling from a transferred colony indicates a negative test.
3. Catalase test
Positive formation of bubbles or effervescence
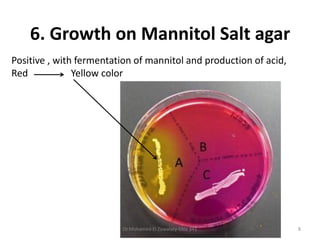
Positive , with fermentation of mannitol and production of acid,
Red Yellow color
6. Growth on Mannitol Salt agar
Dr.Mohamed El Zowalaty-ENV 341 8
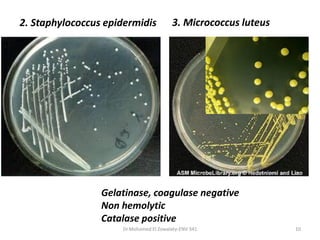
Dr.Mohamed El Zowalaty-ENV 341 10
2. Staphylococcus epidermidis 3. Micrococcus luteus
Gelatinase, coagulase negative
Non hemolytic
Catalase positive
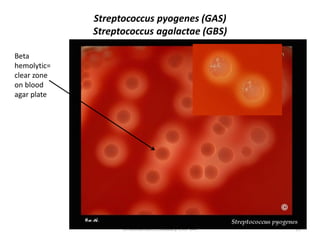
Streptococcus pyogenes (GAS)
Streptococcus agalactae (GBS)
Dr.Mohamed El Zowalaty-ENV 341 15
Beta
hemolytic=
clear zone
on blood
agar plate
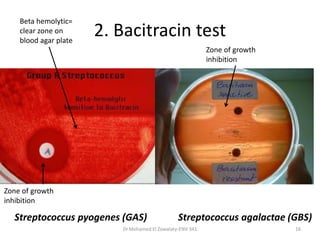
2. Bacitracin test
Dr.Mohamed El Zowalaty-ENV 341 16
Beta hemolytic=
clear zone on
blood agar plate
Zone of growth
inhibition
Zone of growth
inhibition
Streptococcus pyogenes (GAS) Streptococcus agalactae (GBS)
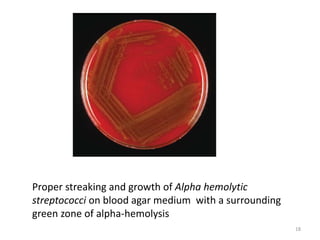
Dr Mohamed Ezzat-ENV 341 18
Proper streaking and growth of Alpha hemolytic
streptococci on blood agar medium with a surrounding
green zone of alpha-hemolysis

This document describes laboratory exercises for identifying different gram positive cocci, including Staphylococcus aureus, Streptococcus pyogenes, and Streptococcus pneumoniae. Identification is based on gram stain morphology, growth characteristics like hemolytic patterns on blood agar, and biochemical tests for catalase, coagulase, optochin sensitivity, and bile solubility. The goal is to differentiate clinically relevant gram positive cocci like S. aureus, S. pyogenes, and S. pneumoniae.